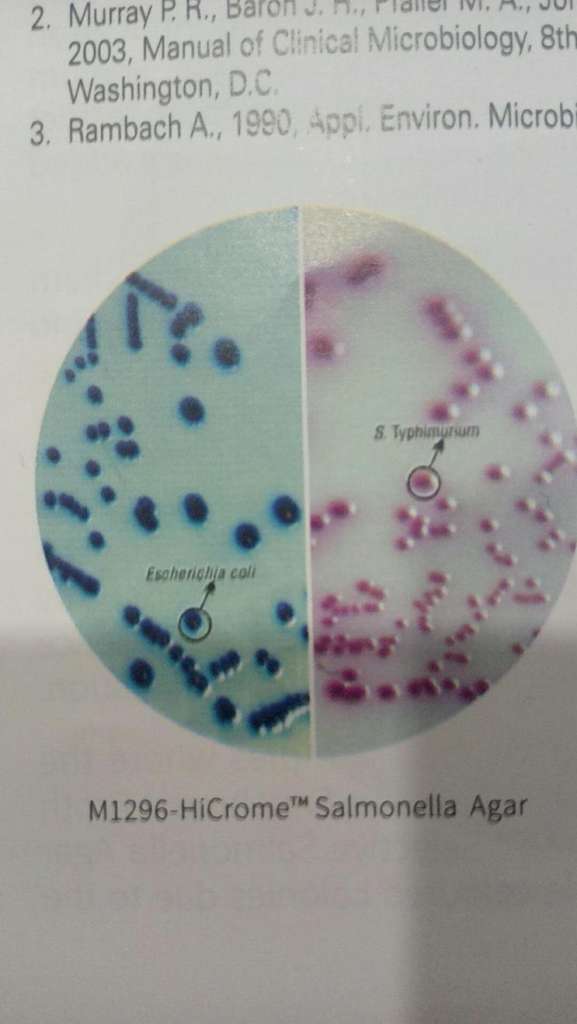
火了！微生物人竟参演了疫苗大片？

9 年
手机商铺
公司新闻/正文
187 人阅读发布时间:2018-01-16 15:22
近日,一部疫苗大片《永不停歇的疫战》备受各方关注,该系列片将从“创新型监测网络”、“检测、发现未知病原体与精准治疗”、“人类共同应对传染病”、“疫苗”、“中医药治疗传染病”5个方面,讲述中国在防治传染病领域创造的世界级科研成果。
中国在世界传染病斗争中作出了不可取代的贡献。而科研和疾病防控人员更是在这场战役中,奋力拼搏,守护人类健康!
电视纪录片总共5集,由国家卫生计生委科教司配合央视中文国际频道栏目组制作。其中,第一集为《永不停歇的疫战》(1)无所遁形。
本期节目从中国与尼泊尔交界的边境小镇讲起,讲述了中国科学家是如何通过世界上最大的传染病网络直报系统将传染病疫情扼杀于萌芽之中;又是如何利用世界上最先进的致病菌识别网从蛛丝马迹中搜寻传染病的源头,阻断传染病的传播途径。

中国疾病预防控制中心主任中国科学院院士高福。
无论是霍乱弧菌、沙门氏菌,如果不能提前鉴别分离,都很有可能带来不可估量的后果。那么选择合适的培养基就尤为重要。其中,作为全球微生物培养三大顶尖品牌之一的HiMedia公司,早就成为各大科研室信赖的培养基厂家。
2014年,HiMedia公司的优秀产品进入中国,并选择威正翔禹生物丨缔一生物作为其在中国地区的总代理和厂家代表。在视频中为我们讲解的中国疾病预防控制中心主任 中国科学院院士高福,也在科研中用到了HiMedia的培养基。
相较传统培养基的检菌(费时、结果不准确),HiMedia的HiCromeTM系列显色培养基采用直观显色鉴定的方法,减少鉴定过程中的猜测,因而不需再传代培养,可显著节省时间。HiMedia的显色培养基品种最为丰富,并且有些品种有非动物源的(包括植物源和化学限定),避免了疯牛病的风险。
针对霍乱弧菌、沙门氏菌的鉴别、分离,小编向大家推荐两款常用的培养基。这两款显色培养基的菌落突出,颜色显著,可有效的实现特异性的不同菌株之间的区分。
培养基1:
M1682 HiCrome Vibrio Agar(弧菌显色培养基)
推荐用于从水产品中分离和选择性鉴别弧菌
具体效果如下(35-37℃培养18-24小时后)

左:霍乱弧菌(紫色)
右:副溶血性弧菌(蓝绿色)
培养基2:
M1296HiCrome Salmonella Agar(沙门氏菌显色培养基)
分离鉴定沙门氏菌,与肠道菌相区分
具体效果如下(35-37℃培养24-48小时后)
左:大肠杆菌(蓝色)
右:鼠伤寒沙门氏菌(淡紫色,有光晕)